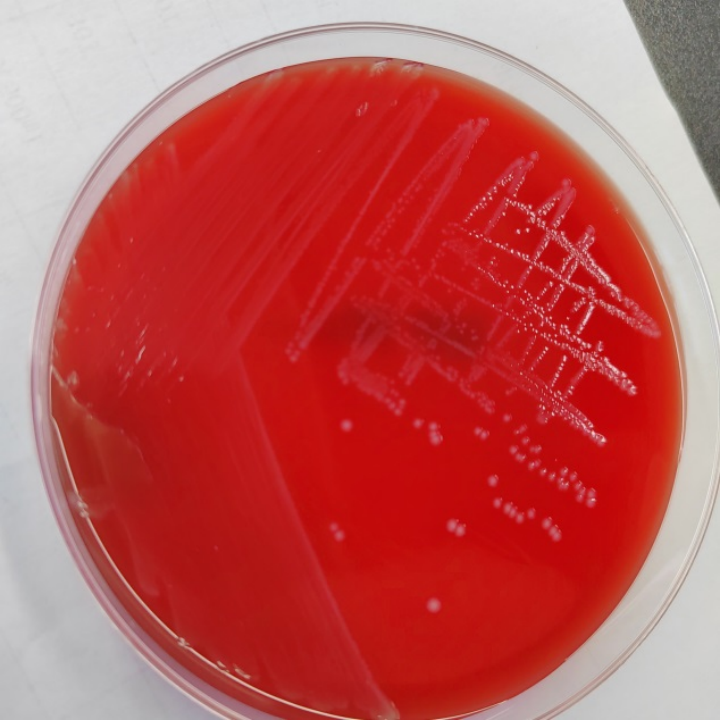

GBS筛查——孕晚期的准妈妈们千万不要错过!
妊娠期女性在孕晚期(35-37周)产检时,医生通常会建议进行GBS筛查。孕妈妈可能会充满各种疑惑,GBS是检查什么的?为什么要检查?为什么都快要生产了才进行检查?怎样进行GBS筛查呢?筛查的意义是什么呢……那今天就让我们来了解一下这个检查吧~

什么是GBS?
无乳链球菌是B群链球菌(Group B Streptococcus,GBS)的唯一成员,因此通常被称为GBS。这种革兰氏阳性菌是人类胃肠道和泌尿生殖道的共生菌,然而它有能力引起严重的感染,属于条件致病菌。
为什么要进行GBS筛查?
GBS感染可引起新生儿早发性脓毒血症、肺炎及脑膜炎等,是导致新生儿早期死亡的主要原因。主要由带菌孕妇通过产道垂直传播而感染胎儿或婴儿。孕妇带菌率为10%~30%,常无临床症状或体征。
GBS的危害主要有哪些?
对产妇的危害 | 对新生儿的危害 |
胎膜早破 | 新生儿败血症 |
菌血症 | 肺炎 |
泌尿系统感染 | 脑膜炎 |
胎膜感染 | 死亡 |
宫内膜感染 | 遗留长期病理状态:耳聋、视力受损、发育障碍以及脑瘫 |
创伤感染 | |
羊膜腔感染 | |
产褥感染 |
GBS筛查为什么是35-37周?
GBS定植状况是变化的,可为一过性、间断性或持续性定植,35-37周这一时间段更能反映定植状态。另外,GBS筛查有效期为5周,若GBS阴性者超过5周未分娩,建议重新筛查。
剖宫产需要筛查吗?
GBS可在阴道分娩时通过母婴垂直传播,也可在剖宫产时通过吸入感染的羊水传播,因此所有孕妇均需要进行筛查。
GBS如何采集?
使用专用女性采样拭子先在下1/3阴道采集阴道拭子再通过肛门括约肌采集直肠拭子,无需使用阴道窥器。

如何进行GBS的检测?
我们实验室已开展细菌培养及B族链球菌检测等技术鉴定GBS。
GBS筛查结果为阳性怎么办?
GBS筛查的目的就是为了早诊断、早干预、早治疗。筛查阳性的孕妈妈在分娩发动或胎膜早破后,依据药敏测试结果使用抗生素,能大大降低新生儿早发性败血症的风险。
妊娠期GBS定植是一个不容忽视的问题。所以对孕妇进行GBS定植筛查,围产期预防性使用抗生素,能够显著减少母婴侵袭性GBS病发生率,保证孕妈妈和宝宝的安全!

下一篇:国际白化病宣传日|集体进步的十年
